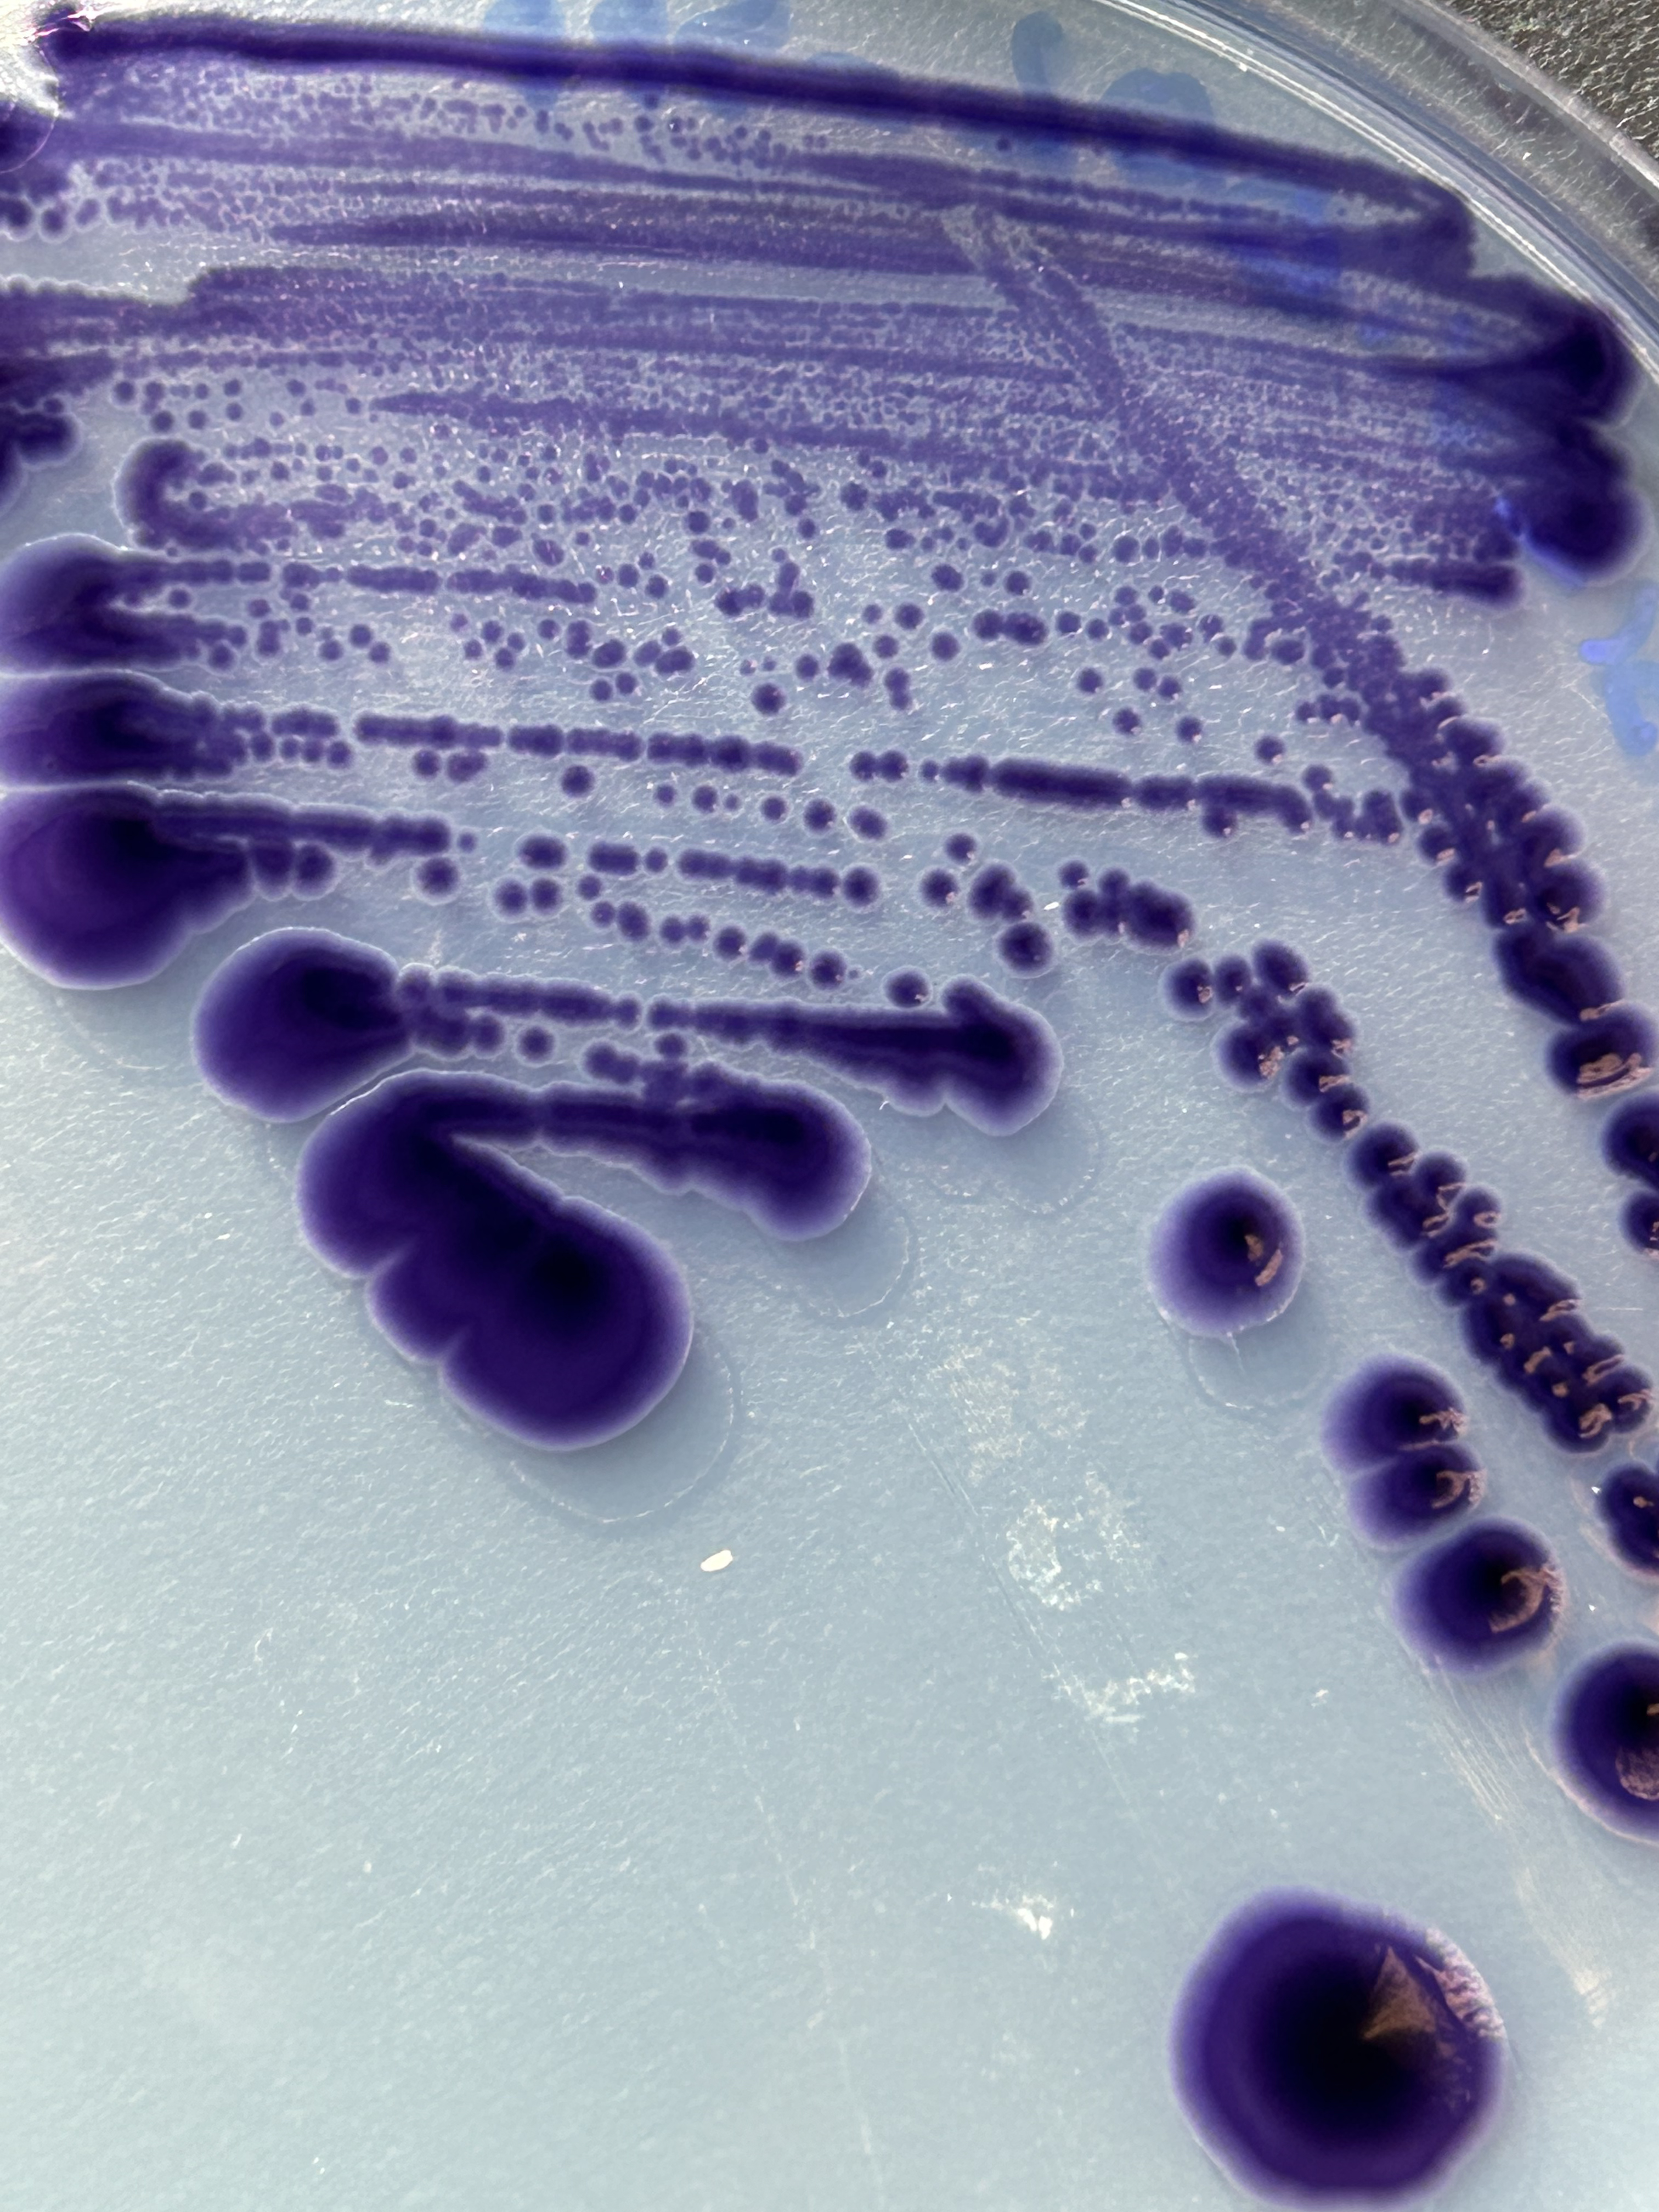

Research Projects
Current Projects
Disentangleing the Role of the Phycosphere in the Thermal Range of Toxic Pseudo-nitzschia spp.
Woods Hole Oceanographic Institution, Advised by Dr. Harriet Alexander

One significant challenge arising at the crossroads of public health and ecosystem management is how harmful algal bloom (HAB) species will change in response to global ocean warming. The domoic acid (DA)-producing diatom genus Pseudo-nitzschia is one of the most common HABs along the U.S. West Coast and has a growing presence in the Gulf of Maine (GOM). In the Monterey Bay in 2015 and the GOM in 2016, anomalously warm water masses triggered toxic Pseudo-nitzschia blooms. Understanding the response of Pseudo-nitzschia to a broad range of temperatures is crucial for comprehending HAB dynamics now and in the future. HAB species are often studied in isolation; however, in the natural environment, interactions between heterotrophic marine bacteria and phytoplankton can greatly influence biogeochemical cycling and microbial community structure and function. This interface, termed the phycosphere, is where bacteria and phytoplankton can exchange molecules. This exchange may make microbes more resilient to thermal stress. Though studies have investigated how ocean warming affects Pseudo-nitzschia cell-physiology, there is limited research on how temperature impacts Pseudo-nitzschia and bacteria interactions. The objective of this research is to understand how bacteria-phytoplankton interactions are impacted by thermal stress and how phycosphere composition and exchange of metabolites impacts a host’s thermal tolerance and bloom dynamics across coastal and open ocean environments. This study will measure the thermal performance of axenic and xenic strains of Pseudo-nitzschia spp. and determine the impact of temperature on bacterial community composition and recruitment. Furthermore, we will isolate individual bacterial members of the Pseudo-nitzschia spp. phycosphere and run a series of pairwise bacteria-phytoplankton co-cultures to understand a synthetic bacterial community to elucidate complex host-microbiome interactions.
Exploring Synergistic Effects of Thermal Stress and Nitrogen Limitation in Gephyrocapsa huxleyi
Woods Hole Oceanographic Institution, Advised by Dr. Harriet Alexander, Contributions by Arianna Krinos
Gephyrocapsa huxleyi (referred to after as G. hux) is a highly abundant and cosmopolitan coccolithophore with a variable pan genome. This genetic diversity may be a driving cause of the success of G. hux in many different environments and niches. While many experiments have looked at the individual effects of nutrient and temperature limitation, looking at the synergistic effects of nutrients and temperature is understudied. This study is looking at two strains (RCC914 and RCCC874) of G. hux at three temperature above the thermal optima in nitrate limited and nitrated replete conditions. The goal is to understand how co-limitation affects the associated bacterial community, the transcriptional repsonse of G. hux, the impact on osmolyte production, and intraspecies differneces.

Past Projects
Characterizing a New Strain of Chromobacterium vaccinii and its Microbial Interactons
Marine Biological Laboratory, Microbial Diveristy Advanced Training Course, Course Directors Dr. John Spear and Dr. Scott Dawson
Since the first purification of violacein from Chromobacterium violaceum by Lasseur and Girardey in 1926, this dark-purple pigment has captured the attention of scientists for nearly a century. Violacein is a bisindole pigment produced by a wide variety of bacteria including Alteromonas, Janthinobacterium, Pseudoalteromonas, Duganella, and Collimonas in a broad range of environments such as deep seas, coastal and freshwater environments, soils, within glacial ice, on the leaves of white clover, and the skin of amphibians. The most well-studied genus is Chromobacterium. In 1945, Lichstein and Van de San discovered the antibiotic properties of extracted violacein from Chromobacterium violacein on both gram-positive and gram-negative bacteria, as well as molds. A study on Staphylococcus aureus shows that this antibacterial property is due in part to the lipophilic nature of violacein. Violacein causes membrane integrity disruption, with increased potassium ion and ATP leakage. Loss of intracellular contents and osmotic balance may then trigger cell death. In the last two decades, violacein has emerged into the spotlight for its pharmacological potential for its biocidal properties including anticancer, antibacterial, antifungal, trypanocidal, antileishmanial, anti-nematode, antiulcerogenic, immunomodulatory and antiviral. Therefore, the isolation of Chromobacterium vaccinii from School Street Swamp, Woods Hole, MA, a swamp characterized by many types of metal metabolism, was an interesting finding worth investigating. The findings of this pilot project detail the phenotypic and genomic characterization of an isolate of Chromobacterium vaccinii and its microbial interactions with bacteria within and outside its natural environment.
Effectiveness of Bloom Mitigtation Strategies for Karenia brevis
Mote Marine Laboratory & Aquarium, Advised by Dr. Vince Lovko

Karenia brevis is a harmful algal bloom (HAB)-forming dinoflagellate that causes Florida Red Tides, resulting in fish kills, death of sea turtles and marine mammals, neurotoxic shellfish poisoning (NSP), and respiratory irritation. The negative impacts of K. brevis blooms create demand for effective mitigation strategies, including physical methods such as clay flocculation and chemical methods such as the naturally derived flavonoids luteolin and curcumin. Cell death is the target of most mitigation strategies; however, the exact mechanisms of how these mitigation compounds affect cellular physiology of K. brevis is still under active research. By targeting physiological processes such as photosynthesis rather than lethality, it is possible to disrupt bloom development while conserving resources and minimizing impacts on non-target organisms and the environment. Experiments were conducted on four strains of K. brevis (New Pass, Wilson Low Toxin, Wilson, and Manasota) to examine the photophysiological responses during exposure to “sub-lethal” concentrations of modified clay (0.1 g/L), curcumin (3 mg/L), and luteolin (3 mg/L). Using Pulse-Amplitude-Modulation (PAM) fluorometry, the quantum yield of Photosystem II (PSII), relative maximum electron transport rate (rETRmax), and absorption cross-section of PSII (σPSII) were measured as the photophysiological parameters. The results demonstrated that curcumin was the most effective compound at reducing photophysiological parameters and cell counts in all tested strains of K. brevis. Clay was the second most effective compound at reducing yield and rETRmax. Luteolin exhibited the least detrimental effect on cell photophysiology. Furthermore, some inter-strain differences were observed. Notably, the Wilson strain was most impacted by luteolin while the other strains were not. Additionally, the photophysiological parameters of Wilson treated with curcumin showed recovery by 24 hours while all other strains did not.

Phytoplankton Ecology on the West Antarctic Peninsula
Rutgers University Center for Ocean Observing Leadership, Advised by Dr. Oscar Schofield

The West Antarctic Peninsula (WAP) is a region experiencing rapid warming, with phytoplankton blooms supporting a productive food web. Light availability and environmental factors including mixed layer depth, wind speed, temperature, salinity, and zooplankton abundance influence phytoplankton size, composition, and productivity. This study examines the impact of biotic and abiotic factors on phytoplankton biomass and community composition at grid line 600 at grid station 40, a seafloor canyon off the coast of Anvers island, using data collected by the Palmer Long-Term Ecological Research program. Plant pigments were used to measure total plant biomass and taxa concentrations of diatoms, cryptophytes, and mixed flagellates. Shallower mixed layer depths (<25 meters) were associated with higher phytoplankton concentrations due to greater light availability. Results revealed diatoms as the most abundant, followed by cryptophytes and mixed flagellates respectively. Cryptophyte abundance was highest in the upper 30 meters, with more light and increased stratification. Warmer water temperatures (>0 °C) and lower salinities (~33 PSU) increased cryptophyte abundance, associated with glacial melt conditions and stronger stratification. Zooplankton and phytoplankton were negatively correlated, suggesting zooplankton grazing plays a significant role in phytoplankton abundance. The changing phytoplankton communities may lead to decreased potential primary production on the WAP.
